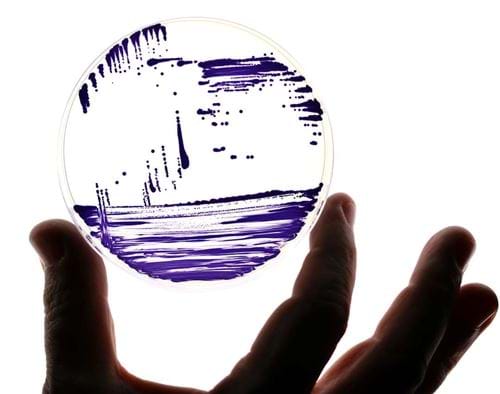

Responsible production, innovation and industry
Ten ways chemical engineers are advancing SDG 12
Why should chemical engineers prioritise responsible production and consumption practices? Plastics, fertilisers, and pharmaceuticals are just a few examples of the products manufactured by the process industries; however, manufacturing can have a significant environmental impact because it consumes energy and water and has potential to emit pollutants and carbon dioxide.

There is growing awareness in the process industries of the importance of responsible production – efficient use of energy and resources, sustainable infrastructure, and providing access to basic services, decent jobs, and a better quality of life for all.
IChemE has made significant contributions that address UN Sustainable Development Goal 12: Responsible Consumption and Production. This article showcases ten recent, relevant IChemE outputs.
Learn more about the UN Sustainable Development Goal 12.
1. Nobel visions: How chemical engineers pave the way to a greener future
Frances Arnold, a Nobel laureate in chemistry, highlights the crucial role of engineers in advancing solutions for pressing global challenges. When she speaks from her own career perspective, Arnold underscores the potential of biotechnology, specifically: directed evolution of enzymes. These evolved enzymes have the capability to transform plant-based materials into jet fuel, enhance energy efficiency in washing machines, and implement industrial processes that minimise environmental harm.

Frances Arnold believes that younger generations are driven by a desire to better the world. To inspire their interest in engineering, she notes that it's essential to showcase how the field directly benefits people and the planet, beyond just profits.
Arnold sees room for engineering education to tap into collaborative and problem-solving aspects of work that young people seek. She stresses the need for educational approaches that prepare students for a world where teamwork is core to addressing significant issues.
Read the full feature in The Chemical Engineer: A Cleaner, Greener Future: ‘We are Key, and we are Responsible’.
2. Using bacteria to dye clothes
Chemical engineers are working to develop technologies that will reduce the environmental impact of textile production. The Chemical Engineer magazine highlights the use of bacteria to produce natural dyes, which decreases use of fossil-based feedstocks that are conventionally used to produce synthetic dyes and reduces the environmental impact of shipping large quantities of dyes.
This technology can be used without modifying existing dyehouse equipment and offers advantages over synthetic dyeing methods, especially in terms of water use and reuse.
The engineers interviewed emphasise the positive contribution that chemical engineers can make in developing sustainable technologies for dyeing and treatment of associated wastewater.
Read the article in The Chemical Engineer: Materials: Making a Positive Difference.
3. Producing hydrogen in a responsible way
Several eminent IChemE members contributed to a report by the UK’s National Engineering Policy Centre (NEPC) on responsible hydrogen production. The report also presents a roadmap for the UK to transition to a hydrogen economy.
The report outlines alternative routes for hydrogen production, and analyses the implications for environmental impact, barriers to large-scale roll-out and the dependencies within hydrogen value chains.

The report identifies the most beneficial applications of hydrogen in a low-carbon energy system, and the most promising technologies for hydrogen production – electrolysis, using renewable energy.
The analysis leads to recommendations for policy development in the short and medium term. Recommendations include investment to demonstrate technologies and accelerate their development, setting up enabling business models, implementing a roadmap for strategically deploying hydrogen, and creating and upholding standards focused on safety and the overall value chain of hydrogen generated using renewable energy.
Read the full National Engineering Policy Centre report: The role of hydrogen in a net zero energy system.
4. How sustainable packaging can become the norm
The paper in the Sustainable Production and Consumption journal by Greenwood and co-authors 'Many Happy Returns: Combining insights from the environmental and behavioural sciences to understand what is required to make reusable packaging mainstream' discusses factors influencing adoption of reusable packaging.

The authors emphasise the role of consumer willingness, design and durability of containers intended for reuse, and appropriate infrastructure.
Specifically, they emphasise that reusable packaging systems can reduce waste significantly and highlight the broader environmental impacts of single-use packaging. They find that, after just two to four uses, refill and return systems using plastic containers for take-away food have a lower global warming potential than single-use plastic containers.
The paper also finds that familiarity with reuse systems and appropriate use of language and terms used to describe them can positively influence consumer behaviour.
If this article has piqued your interest in the circular economy, take a look at the two recent special editions of the same journal. The first special issue, 'Circular Economy and Sustainability: The Role of Technology, Producers, Consumers, and Policy', emphasizes the importance of technology, including blockchain and digital technologies, along with stakeholder engagement, in promoting and advancing the circular economy. The second special issue, 'Circular Economy as a Driver for Achieving Sustainable Production and Consumption', explores various facets of the circular economy, including the challenges and opportunities it presents. This issue also examines the influence of government policies on the circular economy and the implications of new business models for society and the environment.
Explore the two special editions in the Sustainable Production and Consumption journal (member access).
5. Eliminate persistent pollutants
Per- and polyfluoroalkyl substances (PFAS) are synthetic organofluorine chemicals that have been used in a wide range of products, such as nonstick cookware, stain-resistant fabrics, and fire-fighting foams. They are known to be extremely persistent in the environment and to cause a wide range of health issues in humans and other mammals.

Two articles about the problem of PFAS were published in The Chemical Engineer magazine in 2022. In 'Bidding Farewell to the Forever Chemicals', Paul Stevenson discusses the delays in regulatory responses to production and use of PFAS and reducing PFAS contamination of the environment, including drinking water. The article provides an overview of technologies for removing PFAS from water but notes that technologies for destroying PFAS are immature. Stevenson emphasises the role of chemical engineers in developing effective solutions.
A later article discusses the findings of research published in Science in August 2022 on a chemical destruction method that converts PFAS into smaller, less hazardous compounds. The method is deemed promising, but requires further work to allow its implementation at practical concentrations, temperatures, residence times and scales.
Read the articles in The Chemical Engineer: New ‘forever chemical’ elimination method ‘might be the start of something practically interesting’ and 'Bidding Farewell to the Forever Chemicals'.
6. IChemE’s Sustainability Hub aims to inspire and support sustainable practices
The IChemE Sustainability Hub is a rich online resource for chemical engineers who want to learn more about sustainability and how they can contribute.

The hub focuses on four of the UN’s Sustainable Development Goals (SDGs):
- SDG 3: Promote Good Health and Well-Being
- SDG 6: Safe Drinking Water and Sanitation
- SDG 7: Access to Affordable and Clean Energy
- SDG 12: Responsible Production and Consumption
The Hub’s training courses, case studies, and information on the UN SDGs explain the challenges of sustainable production and support chemical engineers’ development of skills to address these challenges.
IChemE will continue to provide members with free content on the Sustainability Hub until the end of 2025.
From February 2022 to October 2023, the Hub has created the following courses:
- An Introduction to Sustainability
- Ethical Decision-Making for Chemical Engineers
- Life Cycle Assessment (LCA) for Chemical Engineers
- The Human Water Cycle: Water and Wastewater Treatment and Reuse
- The Circular Economy for Chemical Engineers
- Sustainable Process Integration for Cleaner Process Design
Planned courses include:
- Role and Responsibility of Chemical Engineers in Achieving Net Zero
- Sanitation and Wastewater Reuse in Developing Regions
- Energy from Waste
- Food Structuring for Achieving Sustainable Development
Visit the Sustainability Hub.
7. From Diet through to Digital: Different ways to achieve the SDGs
From dietary shifts to integrating digital technologies into the circular economy, IChemE’s journal Sustainable Production and Consumption presents a multitude of approaches to advancing SDG 12. In the paper 'Optimising diets to reach absolute planetary environmental sustainability through consumers', Lucas, Guo, and Guillén-Gosálbez – winners of IChemE’s Senior Moulton medal in 2023 – demonstrate the value of embedding 'absolute sustainability' when optimising diets. This framework explores how diet affects the environment. The paper advocates for policies and educational campaigns that prioritise planetary boundaries and point out that food prices in the UK do not reward sustainable dietary patterns.

The insightful literature review 'How the combination of Circular Economy and Industry 4.0 can contribute towards achieving the Sustainable Development Goals' by Dantas and co-authors explores synergies between Industry 4.0 and the Circular Economy (CE). The authors highlight how the integration of digital technologies, such as artificial intelligence and big data, when combined with CE principles, can address multiple SDGs, including SDG 12.
Together, these outputs demonstrate some diverse and innovative ways that chemical engineers can contribute to responsible production and consumption.
Read IChemE’s blog post highlighting other ways chemical engineers address the SDGs: Centenary blog: Spotlight on sustainability and environment.
8. How Circular are Circular Economy Practices? A Value Framework for Evaluating Practices
The paper, by Velenturf and Purnell, presents 'Principles for a Sustainable Circular Economy', defining sustainable circular society as “an equitable society that maintains environmental quality and economic prosperity for current and future generations”. The review of research and practice underlines the need for clarity of scope, evidence-based theory, systematic and holistic approaches, available data, practical tools for rapid assessment and effective decision-making, and enabling policy and legislation.

The authors propose a value framework for a sustainable circular economy that provides the foundations for evaluation of specific circular economy practices.
Ten principles for a sustainable circular economy are set out; these apply whole-system approaches and assessments, foster sustainable solutions through innovation, phase out unsustainable practices and reward circular practices more than resource-intensive practices. The paper recommends that the values and principles are used by stakeholders in society to design, implement and evaluate a sustainable circular economy.
The need to fully integrate the social, environmental and economic dimensions of sustainable development into circular economy is emphasised.
Read the full paper in the Sustainable Production and Consumption journal: Principles for a sustainable circular economy (open access).
9. Replace air separation units with chemical looping schemes
Two recent articles in The Chemical Engineer magazine showcase chemical looping, a promising route for producing (hot) oxygen from air, using oxygen carriers such as metal oxides. The oxygen can then be used to produce chemicals and biofuels – potentially integrated with production of iron, cement, or hydrogen, for example.

A key benefit of chemical looping is that it eliminates the need for the energy-intensive air separation unit typically required for gasification. Chemical looping offers process intensification, reduced capital, and operating expenses. For example, biomass residues can be gasified without extensive pre-treatment.
The authors outline the potential of chemical looping schemes for a variety of applications, highlighting potential reductions in energy losses and facilitation of reactions. To date, large-scale demonstration of the technology is lacking.
The authors emphasise that stimulating scientific development of the concept, with a view to mitigate climate change, will require government intervention.
Read the articles in The Chemical Engineer: A Virtuous Circle: Chemical Looping has Solid Potential for Optimising Processes and Chemical Looping Diversity: Biofuels, Power, CCS and Chemicals.
10. Engaging with governments to shape policies
IChemE has actively engaged with governmental bodies to advocate for sustainable development and to recognise the strategic importance of critical resources. In the UK, IChemE voiced its support for development of onshore solar farms, emphasising their potential in reducing greenhouse gas emissions and aiding the UK in achieving its net zero target. The consultation response stresses the importance of a clear planning framework and continued research into new solar technologies.

Meanwhile, in Australia, IChemE responded to the government's Critical Minerals Strategy, highlighting the significance of these minerals in transitioning to a low-carbon economy.
The response stresses that strategic development of this sector can bolster economic growth, create jobs, and further Australia's climate change objectives. Additionally, IChemE provided feedback on Australia's Low Emissions Technology Statements 2021 (LETS), emphasising the role of chemical engineering in hydrogen production and in carbon capture, utilisation, and storage, as well as in other areas, to lower emissions. IChemE underscores the need for detailed planning, research, and collaboration between governments, industry, and academia to achieve global sustainability goals.
Find out more about how IChemE contributes to policy making.
Where do we go from here?
This overview summarises recent IChemE outputs that attest to the role of chemical engineers in advancing sustainable production and consumption, aligned with SDG 12. By developing solutions that minimise use of resources and waste generation, considering product lifecycles and circular economy, chemical engineers are addressing today's challenges and laying groundwork for a sustainable future.

If you have been inspired by these summaries, you can find out more in our journal Sustainable Production and Consumption. The monthly IChemE CPD Bulletin email also provides invites you to attend upcoming webinars and events, many of which relate directly to responsible production.